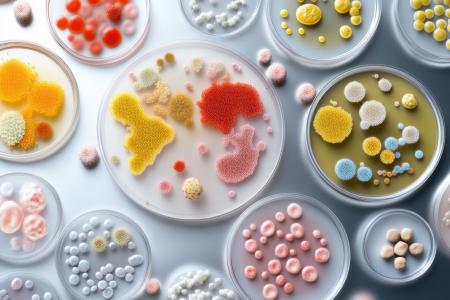
Certaines bactéries intestinales pourraient réduire significativement l'efficacité de certains médicaments (Visuel Adobe Stock 1372624149)

MICROBIOTE INTESTINAL : Il digère mais biotransforme aussi les médicaments
Certaines bactéries intestinales pourraient réduire significativement l'efficacité de certains médicaments, conclut cette équipe de pharmacologues de l’Université de Pittsburgh et de l'Université Yale : leurs travaux, publiés dans la revue Nature Chemistry, décryptent comment ces bactéries intestinales courantes peuvent, en particulier, métaboliser certains médicaments oraux ciblant des récepteurs cellulaires appelés GPCR, ce qui peut réduire leur efficacité thérapeutique.
Pour continuer à lire cette actualité, vous devez être membre Premium.

Je souhaite devenir membre PREMIUM
Accèdez sans limite aux 15 000 actualités du site et recevez gratuitement chaque semaine, la Newsletter Santé log avec les actus Santé à ne pas manquer !

Je suis déjà
membre PREMIUM
Devenez membre PREMIUM
Accèdez sans limite aux 15 000 actualités du site
et recevez gratuitement chaque semaine,
la Newsletter Santé log avec les actus Santé à ne pas manquer !

Je suis déjà membre PREMIUM
Autres actualités sur le même thème
ÉPILEPSIE : Pourquoi le jeûne réduit les crises
Actualité publiée il y a 3 années 5 moisALIMENTS ULTRA-TRANSFORMÉS : Ils prennent aussi la tête
Actualité publiée il y a 3 années 3 moisMICROBIOTE : Une protéine qui lui veut du mal
Actualité publiée il y a 1 année 5 moisAUTISME : Un effet révolutionnaire prosocial des opioïdes
Actualité publiée il y a 12 mois 4 jours
ABONNEMENT PREMIUM
Accédez sans limite à plus de 15 000 actualités




